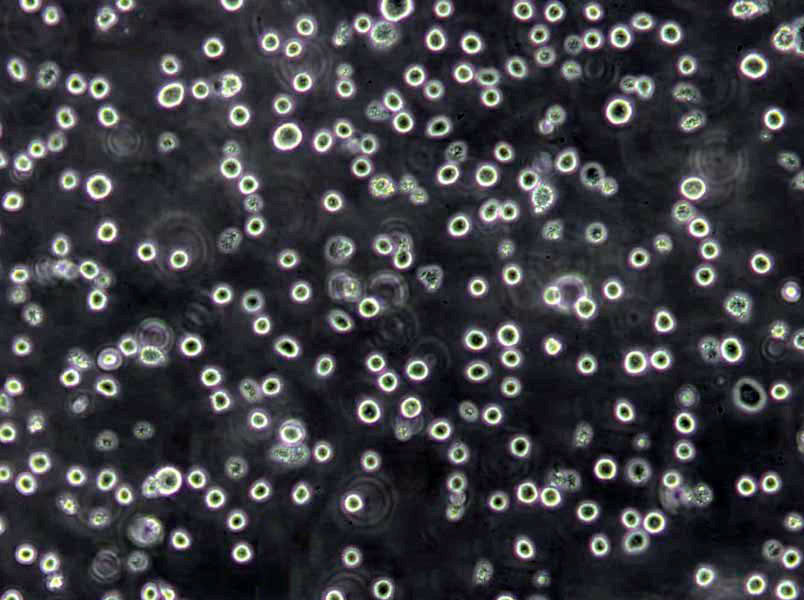
TALL-104 Cells(赠送Str鉴定报告)|人急性T淋巴细胞白血病细胞

"TALL-104 Cells(赠送Str鉴定报告)|人急性T淋巴细胞白血病细胞
细胞背景资料:急性T淋巴细胞白血病;男性
细胞形态:淋巴母细胞样
解冻细胞常见实验问题分析及推荐解决方法:在解冻冻存细胞时,发现会出现存活率低、大量细胞碎片及生长缓慢等问题,究竟是什么原因导致,我们该怎么进行解决?以下是国内外细胞培养专家针对解冻细胞实验问题,总结的一些解决方案!出现低存活率的可能原因及推荐解决方案如下:1)解冻过程中细胞裂解,推荐的解决方案:可预期到一定量的细胞死亡,因此细胞的浓度应足够GAO,考虑到这一损失。起始浓度为1*10(6)至1*10(7)细胞/毫升;2)解冻过程中的问题,推荐的解决方案:在-70℃至-80℃下保存冷冻的培养物,保存时间为1-5天,但这不是保存的方法。在37℃充分解冻后应立即开始培养;3)对冷冻液过敏,推荐的解决方案:A.完全或部分更换培养基,减少培养基中冷冻液的量。在24小时后更换培养液体可全部去除冷冻液。B.留出更多时间供培养物恢复。有时细胞需要几周时间才能形成单层或密集的悬浮物,取决于冷冻时细胞的年龄或传代次数或在生长阶段中的位置。冷冻的Zui佳条件在对数期;4)被冷冻的原种细胞的年龄或冷冻时培养物的年龄,推荐的解决方案:解冻Zui近冷冻的细胞。细胞处于冷冻状态的时间越长,存活率越低。检查冷冻细胞的时间和方法。在冷冻时细胞应处于对数期。
细胞生长:悬浮
D10细胞类似产品::HDLM2细胞、ACC-2细胞、AAV293细胞
REC1细胞类似产品::MKN-7细胞、HEMCSS细胞、CEM clone 7细胞
NCI H157细胞类似产品::Hs-606-T细胞、HPAF/CD18细胞、KGN细胞
MD Anderson-Metastatic Breast-231细胞类似产品::95D细胞、Hs 940.T细胞、UACC812细胞
hTERT RPE1细胞类似产品::RPMI-8226细胞、MHCC97-H细胞、H-2108细胞
TALL-104 Cells(赠送Str鉴定报告)|人急性T淋巴细胞白血病细胞
细胞物种来源:人源或鼠源等其它物种来源
[细胞产品包装]鲜活细胞:T25培养瓶(一瓶)或冻存细胞:1ml冻存管(两支)
传代的操作步骤注意事项:1)操作前要洗手,进入超净台后手要用75%酒精或0.2%新洁尔灭擦试。试剂等瓶口也要擦试。2)点燃酒精灯,操作在火焰附近进行,耐热物品要经常在火焰上烧灼,金属器械烧灼时间不能太长,以免退火,并冷却后才能夹取组织,吸取过营养液的用具不能再烧灼,以免烧焦形成碳膜。3)操作动作要准确敏捷,但又不能太快,以防空气流动,增加污染机会。4)不能用手触已消毒器皿的工作部分,工作台面上用品要布局合理。5)瓶子开口后要尽量保持45℃斜位。6)吸溶液的吸管等不能混用。贴壁细胞传代的操作步骤:1)吸除培养瓶内旧培养液。2)向瓶内加入胰蛋白酶和EDTA混合液少许,以能覆满瓶底为限。3)置温箱中2-5分钟,当发现细胞质回缩,细胞间隙增大后,立即终止消化。4)吸除消化液,向瓶内注入Hanks液数毫升,轻轻转动培养瓶,把残余消化液冲掉。注意加Hanks液冲洗细胞时,动作要轻,以免把已松动的细胞冲掉流失,如用胰蛋白酶液单独消化,吸除胰蛋白酶液后,可不用Hanks液冲洗,直接加入培养液。5)用吸管吸取营养液轻轻反复吹打瓶壁细胞,使之从瓶壁脱离形成细胞悬液。6)计数板计数后,把细胞悬液分成等份分装入数个培养瓶中,置温箱中培养。悬浮细胞传代的操作步骤:1)吸出细胞培养液,放入离心管中,离心1000rpm5分钟。2)吸掉上清液,加入适量之新鲜培养基,混和均匀后,依稀释比例转移至新的培养瓶中,以正常培养条件培养。
细胞传代方法:1:2-1:3传代;每周换液2-3次。
SW-1573细胞类似产品::MDBK (NBL-1)细胞、IM 9细胞、NR 8383细胞
BV173细胞类似产品::RGC-5细胞、RBL.2H3细胞、HS-445细胞
HCC0827细胞类似产品::RPMI-8402细胞、3 LL细胞、IBRS-2细胞
H1792细胞类似产品::IM9细胞、Caco-2BBe细胞、MRC-V细胞
HO-8910 PM细胞类似产品::CL-40细胞、H-2227细胞、NCI-H345细胞
细胞来源说明:来源于RCB、ATCC、KCLB、DSMZ、ECACC、INCell、ScienCell、ECACC、JCRB、Asterand、ICLC等知名细胞库
TALL-104 Cells(赠送Str鉴定报告)|人急性T淋巴细胞白血病细胞
细胞生长特性:悬浮
TKB1细胞类似产品::Anip[973]细胞、GM05862细胞、NCI-H1694细胞
FU-MMT-1细胞类似产品::KG-1a细胞、H-522细胞、SK-Mel 2细胞
SK Col 1细胞类似产品::KOSC-2细胞、NCIH2228细胞、NCI H929细胞
IOSE80细胞类似产品::NCI-H69C细胞、Jurkat E6-1细胞、MGECs细胞
H676细胞类似产品::HCC38细胞、SKMES-1细胞、BC-025细胞
DHL6细胞类似产品::KASUMI6细胞、C22细胞、LM(TK-)细胞
造成实验室细胞污染常见情况总结:细胞培养中Zui常见污染的是细菌、真菌和支原体污染。细胞一旦污染,大多数较难处理。那么,哪些情况我们不注意的话就会造成细胞污染呢?我们根据常见细胞培养实验分析总结下。【违规操作】1)为节省时间,有人已经用超净台四个多小时,不开紫外灭菌30min,酒精擦拭后直接开始试验;2)器材或者溶液很久没用,未检测是否污染而直接使用;离心管多次使用,枪头为了方便交叉使用;3)超净台不点酒精灯;点了酒精灯放在右上角,而你在左下角做试验;4)不带手套,徒手操作;5)细胞培养间配备枪式移液器、手术器械、离心机、冰箱等专用仪器设备以及专用的实验服和拖鞋,未定期消毒。专用物品被带出传代细胞使用。培养细胞过程中使用的所有实验用具,如移液管、一次性枪头、一次性塑料离心管、冻存管等未按要求灭菌使用(通常需121°CGAO压灭菌20分钟后37%烤干备用)。超净台和桌面,东西太多太乱:超净台不是储物箱,什么培养皿、各种规格的板子、枪头就不要堆在超净台!这样就会有许多紫外线顾不到的卫生死角。传代细胞其他的桌面,切忌东西堆积如山,不要将酒精棉球、标签纸、牛皮纸买来后全部堆在传代细胞!一不小心“飘”进你的细胞培养板里,细胞就会养的不HAO,啥时候死了都不知道!【培养箱太久没清洁】细胞污染了,并非直接扔了培养皿就不管了,首先你还得看看这个恒温培养箱里其他培养皿或孔板里的细胞是否污染,如果有而且HAO几个板子都有类似的污染块,那很可能是培养箱中的水或者空气污染了,得给培养箱做个大扫除,重新酒精消毒,照紫外;孵箱里的水,水没了要记得加,还得记得十天半个月的就用酒精擦擦托盘。【传代细胞人多口杂,难管理】在传代细胞这种卫生要求GAO,人多了,不确定因素多了,难以保证试验在无菌条件下操作。出入试验室,实验服当风衣穿,不扣纽扣,不戴,就容易造成细胞污染;超净台做实验时,喜欢说话聊着做试验,要是还不带口罩,里面就有很多细菌等着去攻击你的细胞呢!
贴壁细胞消化传代时通常采用两种方法:一、加入胰酶等细胞脱落后,再加培养基中止胰酶作用,离心传代;二、加入胰酶后,镜下观察待细胞始脱落时,弃胰酶,加培养液分瓶。但前者太麻烦,而后者有可能对细胞施加胰酶选择,因为总是贴壁不牢的细胞先脱落,对肿瘤细胞来说,这部分细胞有可能是恶性程度较GAO的细胞亚群。一种简单的消化传代方法。加入PBS洗去血清或加入胰酶先中和血清的作用(30s),弃之,再加入适量胰酶作用10s-40s(根据细胞消化的难易程度),弃之,这样依赖残余的胰酶就可将细胞消化单细胞。对于较难消化的细胞,可以用2%利多卡因消化5-8分钟,然后再弃去,加培养基吹打也可以,对细胞的影响不大。不用PBS也不用Hanks洗,只要把旧培养液吸的干净一点,直接加酶消化应该不会有什么问题。弃培养液后,用0.04%的EDTA冲洗一次,再用1/4v的0.04%的EDTA室温孵育5min,弃取大部分EDTA,加入与剩余EDTA等量的胰酶(预热)总体积1/10v。消化到有细胞脱落。不过有人说EDTA对细胞不HAO,有证据吗?培养的BASMC:倒掉旧培养液加入少量胰酶冲一下,倒掉再加入0.125-0.25%胰酶约6-10滴或1ml(25ml bottle)消化再加入适量新培养基中和,并分瓶这种方法简单、省事;效果很HAO并且不损失细胞!
Adeno-293细胞类似产品::VMRC-LCD细胞、TSCC1细胞、8402细胞
U-373MG细胞类似产品::Astrocyte type I clone细胞、FU-97细胞、DoTc2 4510细胞
Rat Glomerular Endothelial细胞类似产品::NCIH747细胞、JeKo-1细胞、NCI747细胞
NCIH1755细胞类似产品::FET细胞、RGM-1细胞、MILE SVEN1细胞
DR2R 1610细胞类似产品::GNM细胞、DLD 1细胞、Panc2_03细胞
UCLA NPA871细胞类似产品::MADB106细胞、A2780 CP70细胞、MDAMB361细胞
TOG细胞类似产品::Human Epidermoid carcinoma #2细胞、H441细胞、CCRF-SB细胞
RERFLCMS细胞类似产品::DI TNC-1细胞、Murine Leydig Tumor Cell line-1细胞、CV-1 in Origin Simian-1细胞
NCI-H1666细胞类似产品::Mouse Bladder Tumor line-2细胞、MDA-MB-435 S细胞、GM02131细胞
H1299细胞类似产品::C-4-I细胞、Jurkat细胞、T8细胞
TM4细胞类似产品::UC-3细胞、CWR22R-V1细胞、TE-11细胞
PLC/PRF/5细胞类似产品::Ramos.G6.C10细胞、HEY A8细胞、OS-RC-2细胞
Hs819T细胞类似产品::HS-766-T细胞、U2OS细胞、INS1-E细胞
LOUNH91细胞类似产品::CCD-112 CoN细胞、HSC-T6细胞、Vx-2细胞
KNS-42细胞类似产品::P-388D1细胞、mRMEC细胞、T47-D细胞
Colo16细胞类似产品::HBMEC细胞、NCIH520细胞、Wills Eye Research Institute-Retinoblastoma-1细胞
OCI AML3细胞类似产品::SW 839细胞、MOLP-8细胞、OVISE细胞
Sp2/mIL-6细胞类似产品::MDAPCa2b细胞、WM239A细胞、UCLA RO-81-A-1细胞
NCIH810细胞类似产品::NCI-H2126细胞、NFHIOSE-29细胞、LS513细胞
U-343-MG细胞类似产品::OUMS-27细胞、CMT 93细胞、H1568细胞
NCI-H510细胞类似产品::NCI-H1755细胞、BE(2)M17细胞、BI-Mel细胞
SKNO1细胞类似产品::MDA-MB-175VII细胞、HCC-1937细胞、CT26细胞
C6细胞类似产品::NCIH1975细胞、GNM细胞、MUTZ-3细胞
CW2细胞类似产品::Epstein-Barr-2细胞、MJ细胞、HS 683T细胞
Chinese Hamster Lung细胞类似产品::H-1568细胞、PNT1-a细胞、COLO-320-DM细胞
MMAc-SF细胞类似产品::HEB细胞、Kit-225-K6细胞、MB157细胞
RASMC细胞类似产品::OCI-Ly8细胞、TPC-1细胞、WSU-DLCL-2细胞
Henrietta Lacks cells细胞类似产品::IM 9细胞、OVHM细胞、MOLT16细胞
RA.1细胞类似产品::TT细胞、H-1092细胞、COLO 680N细胞
SKNBE-2细胞类似产品::Laboratory of Allergic Diseases 2细胞、IMCD3细胞、SCL I细胞
DoHH2细胞类似产品::VMRCRCZ细胞、KYSE 180细胞、H-2291细胞
Co 115细胞类似产品::COLO829细胞、JHH7细胞、NCIH1688细胞
BC-025细胞类似产品::Ramos G6.C10细胞、Human Microglia Clone 3细胞、NCI-H748细胞
CD 18细胞类似产品::KU1919细胞、Earle's L cells细胞、HR-8348细胞
VMM5A细胞类似产品::CX-1细胞、Fox/NY细胞、7860细胞
no.11细胞类似产品::HCE-2 [50.B1]细胞、THC-8307细胞、HCA-7细胞
CCF-STTG1细胞类似产品::MT-2J细胞、ME 180细胞、NCI-H1184细胞
SNU1040细胞类似产品::16HBE14o-细胞、PLA-801D细胞、RSC 96细胞
SCC VII细胞类似产品::AN3-CA细胞、Lilly Laboratories Cell-Monkey Kidney 2细胞、MFE296细胞
MC38细胞类似产品::QG56细胞、H-1238细胞、OCM1A细胞
HCC1008细胞类似产品::HCC1588细胞、REC细胞、SNU-16细胞
TALL-104 Cells(赠送Str鉴定报告)|人急性T淋巴细胞白血病细胞
K7M2细胞类似产品::GM03569D细胞、Pro-Lec1.3C细胞、NCI-H1092细胞
CoC1细胞类似产品::D324细胞、L540细胞、74Int细胞
MKN-74细胞类似产品::RMS 1598细胞、IHHA-1细胞、alpha-TC1-6细胞
SRS-82细胞类似产品::BIC-1细胞、MDA-MB415细胞、UMNSAH-DF-1细胞
SGC 7901细胞类似产品::U-2932细胞、UK Pan-1细胞、P30/0HK细胞
MES 13细胞类似产品::MCA38细胞、HLEB-3细胞、SUM 149PT细胞
Capan1细胞类似产品::SK-RC-20细胞、UWB1-289细胞、HRMC细胞
BIC细胞类似产品::NCI-H1563细胞、Adeno 293细胞、Panc-3_27细胞
NOR-10细胞类似产品::ROS-17/2.8细胞、H146细胞、SKNFI细胞
TE-6细胞类似产品::SK MEL 28细胞、MFC细胞、REC-1细胞
NH-6细胞类似产品::SKNBE-2细胞、HS0578T细胞、SK-MES1细胞
Hs 695.T细胞类似产品::HSC6细胞、IBRS-2细胞、CHL-11细胞
T-98细胞类似产品::SKml2细胞、MKN-28细胞、MDCK Type II细胞
BC-3-H-I细胞类似产品::CHP126细胞、Lewis Lung细胞、NBL-3细胞
BC-3-H-I细胞类似产品::CHP126细胞、Lewis Lung细胞、NBL-3细胞
HCC0070细胞类似产品::NCIH1395细胞、TO 175.T细胞、DHL-16细胞
C-28I2细胞类似产品::RPPVEC细胞、H-1650细胞、NCI-H1993细胞
GOS3细胞类似产品::NCIH660细胞、H-28细胞、LAN-1细胞
NCIH209细胞类似产品::LA-N-5细胞、Capan 1细胞、VE细胞
KP-4细胞类似产品::ES-2细胞、IR983F细胞、P-19细胞
COLO 829细胞类似产品::F81细胞、Swiss3T3细胞、SK-UT-1细胞
SUM 52PE细胞类似产品::OKa-C-1细胞、HT 1376细胞、NCI-H2198细胞
P388.D1细胞类似产品::SKHEP1细胞、BT 549细胞、U-87MG ATCC细胞
NL20细胞类似产品::RIN m5F细胞、MLFC细胞、LTEP-sm 1细胞
SKNDZ细胞类似产品::751-NA-15细胞、HCC366细胞、PFSK-1细胞
769-P细胞类似产品::143B细胞、MA 104细胞、RBE细胞
C127细胞类似产品::M 1细胞、PTK 1细胞、TE6细胞
LN-382细胞类似产品::W256细胞、SVGp12细胞、U-266细胞
SK-ES-1细胞类似产品::CD18/HPAF细胞、GCT细胞、N87细胞
ROS 17/28细胞类似产品::A-427细胞、BpRcl细胞、Ly19细胞
C-127细胞类似产品::McARH7777细胞、TOV112细胞、BPH-1细胞
HCC2185细胞类似产品::BEL-7402细胞、CCD-33Co细胞、B16/F0细胞
NP69细胞类似产品::H-2023细胞、LM(TK-)细胞、NCI-H1573细胞
Mono Mac 6细胞类似产品::CCD-841CoN细胞、Walker-Ca.256细胞、Hs 578Bst细胞
UCH1细胞类似产品::HBZY1细胞、H-650细胞、P3J HR1-K细胞
NCI-H1618细胞类似产品::3396细胞、H-1417细胞、SNU-1细胞
OCILY3细胞类似产品::Madison细胞、mouse Inner Medullary Collecting Duct-3细胞、HEK AD293细胞
MV3细胞类似产品::TE7细胞、IHH-4细胞、RD-2细胞
WC00079细胞类似产品::A549ATCC细胞、MKN74细胞、D 407细胞
HEK-293H细胞类似产品::SGC7901/DDP细胞、H1650_CO细胞、10T1/2细胞
N-87细胞类似产品::108CC15细胞、Hs 895 T细胞、KYSE 520细胞
VMRCRCZ细胞类似产品::BE(2)-C细胞、SL1细胞、NU-GC-3细胞
HF-91细胞类似产品::TE-7细胞、10T1/2细胞、Ramos-RA1细胞
MKN-45细胞类似产品::SHSY-5Y细胞、HPB/ALL细胞、MCF-7细胞
ARH77细胞类似产品::H-9细胞、SNU407细胞、P19细胞
WI 38细胞类似产品::GM-346细胞、MOLT-4细胞、Okayama University Medical School-27细胞
SEM细胞类似产品::LTEP-a2细胞、OC-3-VGH细胞、WM115细胞
NCI-H345细胞类似产品::MOVAS-1细胞、MAC1细胞、K-1735细胞
HEI-193细胞类似产品::HNSC细胞、NIH:OVCAR-5细胞、NCI-H1819细胞
Hs746T细胞类似产品::CEMC1细胞、TE-6细胞、U-87细胞
PaTu-8988s细胞类似产品::8305-C细胞、EBC-1/original细胞、SCC154细胞
Y3.AG.1.2.3细胞类似产品::Rat Fetal Lung-6细胞、MES-SA/Dx5细胞、TALL 1细胞
RH7777细胞类似产品::KALS-1细胞、HCC-827细胞、NCI-128细胞
HCV 29细胞类似产品::Ly19细胞、Ontario Cancer Institute-Acute Myeloid Leukemia-5细胞、OSRC2细胞
T-HEECs细胞类似产品::QBI-HEK 293A细胞、MV4;11细胞、MDA134细胞
T-cell Acute Lymphoblastic Leukemia-1细胞类似产品::Hs 766细胞、H-676细胞、RPVSMC细胞
DC 2.4细胞类似产品::526细胞、HFLS-OA细胞、NBL-S细胞
NOZC-1细胞类似产品::F442A细胞、MFE-280细胞、Hs 636.T细胞
Mouse Bladder Tumor line-2细胞类似产品::NPA87-1细胞、Porcine Kidney-15细胞、IPLB-SF-21细胞
Ca Ski细胞类似产品::Tb 1 Lu (NBL-12)细胞、University of Michigan-Urothelial Carcinoma-14细胞、D-407细胞
NIH:OVCAR-8细胞类似产品::X63-Ag8.653细胞、QBI-HEK 293A细胞、IEC-6细胞
H2052_MM细胞类似产品::SNU-368细胞、GBCSD细胞、WM 451-Lu细胞
SNU-668细胞类似产品::Mac-1细胞、EU-4细胞、NCI-H660细胞
L 363细胞类似产品::WEHI 3B细胞、MDCK.2细胞、LU451细胞
N1E-115细胞类似产品::87MG细胞、MDA-MB-175-VII细胞、AML193细胞
2B4细胞类似产品::MOPC细胞、PK 15细胞、KY180细胞
Mia PACA 2细胞类似产品::U118细胞、Ramos 1细胞、GM06141B细胞
Panc327细胞类似产品::KPL-1细胞、BEL-7402细胞、COLO-320HSR细胞
D-283MED细胞类似产品::293 Ad5细胞、KMS-18细胞、P3-NS1/1-Ag4-1细胞
H82细胞类似产品::FRTL-5细胞、H596细胞、OCM-1细胞
DMS273细胞类似产品::CF PAC-1细胞、CC-LP-I细胞、P-815细胞
2PK3细胞类似产品::NIH 3T6细胞、Lewis-Lung细胞、NTERA2D1细胞
GTL-16细胞类似产品::H35 Reuber细胞、SNG-M细胞、Colo205细胞
Hs 274细胞类似产品::CFPAC-1细胞、TK-10细胞、AML 12细胞
MILE SVEN 1细胞类似产品::AN3 CA细胞、Ha Fe细胞、GM04154细胞
HMy2.CIR细胞类似产品::P3X63 Ag8.653细胞、OCI/AML3细胞、MC-38细胞
NOK细胞类似产品::Biologics Standards-Cercopithecus-1细胞、RPMI 1846细胞、DoHH2细胞
OVCAR-10细胞类似产品::IAR20细胞、NK-92MI细胞、Hs 895.T细胞
SW900细胞类似产品::NCI-H510细胞、HCA7细胞、BxPC-3细胞
IPI-2I细胞类似产品::KP-N-RT-BM-1细胞、Hs870T细胞、TE-14细胞
Jiyoye (P-2003)细胞类似产品::H-1299细胞、COS1细胞、HMCB细胞
HEK/EBNA细胞类似产品::K 562细胞、HT3细胞、NCI-H1693细胞
C3H10T1/2 clone8细胞类似产品::COS-1细胞、MCF10A细胞、NCIH322细胞
GM03571细胞类似产品::Fetal Rhesus Kidney-4细胞、HCC-1395细胞、SU86.86细胞
NCI H157细胞类似产品::Hs-606-T细胞、HPAF/CD18细胞、KGN细胞
QBC(939)细胞类似产品::HSC(Human Schwann)细胞、ARPE-19细胞、MuM-2C细胞
TNC-1B12B4细胞类似产品::Pa18C细胞、G-402细胞、U373MG细胞
PaCa2细胞类似产品::NTera-2D1细胞、118MG细胞、OCILY19细胞
HEK (AD293)细胞类似产品::WI 38细胞、HT 1197细胞、BAEC细胞
SCC 9细胞类似产品::MLE-12细胞、SK-MEL-24细胞、GM03671C细胞
CTLL(2)细胞类似产品::KU-19-19细胞、SLMT-1细胞、MC9细胞
H-2347细胞类似产品::Anglne细胞、WM-239细胞、TCC Sup细胞
NCI-N87细胞类似产品::NRK细胞、NCI-H2196细胞、Fetal Bovine Heart Endothelial细胞
NCI-H661细胞类似产品::MDA-MB-231细胞、NCI H295R细胞、RetroPack PT67细胞
EA. hy 926细胞类似产品::SUM190PT细胞、THLE-2细胞、AU 565细胞
VeroC1008细胞类似产品::Bronchial Epithelium transformed with Ad12-SV40 2B细胞、CEMO-1细胞、EST81细胞
IOSE 29细胞类似产品::293-EBNA1细胞、F442A细胞、Hx147细胞
KASUMI6细胞类似产品::NCIH1435细胞、OCI/AML-3细胞、RMG1细胞
LAN-1细胞类似产品::NCIH460细胞、KMM1细胞、BTI-Tn5B14细胞
WM239A细胞类似产品::PC-3M-IE8细胞、OVCAR420细胞、TCMK1细胞
CMECs细胞类似产品::H-1573细胞、JHH2细胞、mREC细胞
NCI-H647细胞类似产品::HCCLM6细胞、SPC-A-1细胞、Intestinal Epithelioid Cell line No. 6细胞
IOSE-Mar细胞类似产品::4T1-A细胞、GM02132细胞、SEG1细胞
OUMS-27细胞类似产品::KYSE270细胞、Alpha Mouse Liver 12细胞、MHCC-LM3细胞
NFS-60细胞类似产品::Hs-600-T细胞、MDA2B细胞、BERH-2细胞
BC-025细胞类似产品::Ramos G6.C10细胞、AE1201细胞、HPDE6c7细胞
Hk-2细胞类似产品::L M (TK-)细胞、JB6Cl30细胞、MNNG-HOS (Cl#5)细胞
H196细胞类似产品::WM-2664细胞、HcaF细胞、GM01232细胞
SCC 15细胞类似产品::VeroC1008细胞、NCI-H522细胞、MV4-11细胞
RS 4;11细胞类似产品::MPC5细胞、H-1404细胞、D-341 Med细胞
NCIH2347细胞类似产品::SW-48细胞、MFE296细胞、KOPN8细胞
HPBALL细胞类似产品::HBL100细胞、FDCP1细胞、3T3-F442A细胞
SUP-T1细胞类似产品::N-2a细胞、A-431细胞、SN12C细胞
16HBEo-细胞类似产品::NCIH3255细胞、MH7A细胞、aNK细胞
HTori:3细胞类似产品::KBM-7/Hap8细胞、H4-II-E细胞、SCC7细胞
HCT_116细胞类似产品::RT4-D6P2T细胞、Hs-675-T细胞、WB F344细胞
118MG细胞类似产品::SUP-B1细胞、Detroit 562细胞、LM1细胞
WiDr细胞类似产品::HPAF细胞、TOV-112细胞、L cell细胞
THLE2细胞类似产品::7860细胞、SCC90细胞、SNK-6细胞
TALL-104 Cells(赠送Str鉴定报告)|人急性T淋巴细胞白血病细胞
HIEC-6细胞类似产品::GM04679细胞、SW1573细胞、RPMI2650细胞
NBL-4细胞类似产品::UMRC-2细胞、Simpson细胞、NCI-H498细胞
L M (TK-)细胞类似产品::UT-7细胞、FRTL-5细胞、58F细胞
C4-2细胞类似产品::BC-024细胞、NCI-H1693细胞、MDAMB453细胞
UCLA-RO 81细胞类似产品::M-14细胞、HTori:3细胞、MDA.MB.231细胞
KRCY细胞类似产品::MDCK-II细胞、Ly18细胞、MDA231-LM2细胞
CLONE M3细胞类似产品::P3-X63-Ag 8.653细胞、A3细胞、HPAF-II细胞
SW1463细胞类似产品::H69细胞、SF539细胞、TE1细胞
HCC-1806细胞类似产品::D324 Med细胞、RBL 2H3细胞、HCS2/8细胞
SCC25细胞类似产品::Hs-940细胞、Intestinal Epithelioid Cell line No. 6细胞、P3-Jiyoye细胞
526 mel细胞类似产品::RTE细胞、293-EBNA细胞、Biologics Standards-Cercopithecus-1细胞
SNU216细胞类似产品::MyLa 2059细胞、DI-TNC1细胞、HeLa细胞
MSB-1细胞类似产品::WEHI3细胞、MC57细胞、NBL-5细胞
Hs 683.T细胞类似产品::TPC1细胞、RPTC细胞、HS5细胞
L-Wnt-3A细胞类似产品::MC3T3-E细胞、A-172细胞、RPMI-1788细胞
KNS-42细胞类似产品::P-388D1细胞、mRMEC细胞、T47-D细胞
Panc3_27细胞类似产品::PG13细胞、Hs 746.T细胞、SVG p12细胞
H-1436细胞类似产品::PNT1/A细胞、SUM-52-PE细胞、Hca-F细胞
MFE-296细胞类似产品::PIG1细胞、H-747细胞、A375mel细胞
P-3J细胞类似产品::TE14细胞、NCI-H1944细胞、VMCUB-1细胞
P1-Raji细胞类似产品::RCC-10RGB细胞、MG-HU-3细胞、OCI-AML-5细胞
Huh 7.5细胞类似产品::MiaPaCa2细胞、Lewis Lung Cancer细胞、SUM 190细胞
Hs27F细胞类似产品::LWnt3A细胞、IPLB-Sf21-AE细胞、HLEpiC细胞
2BS细胞类似产品::alphaTC1 Clone 6细胞、NCI-H2030细胞、H69细胞
H-209细胞类似产品::253J-BV细胞、UCLA RO-81A-1细胞、KS-1 [Human glioblastoma]细胞
QBC939细胞类似产品::HRA-19细胞、TE9细胞、C518细胞
Li-7细胞类似产品::NCTC clone 929细胞、Balb/3T3-4-Cl31细胞、VM-CUB-I细胞
Swiss 3T3细胞类似产品::JROECL 19细胞、624细胞、HNE2细胞
KASUMI6细胞类似产品::NCIH1435细胞、TE1细胞、Hs683T细胞
HCGC细胞类似产品::BC3H-1细胞、Fao细胞、OCI-AML-2细胞
Rat Glomerular Endothelial细胞类似产品::NCIH747细胞、MDA-361细胞、Leukemia 1210细胞
H1623细胞类似产品::NCTC-1469细胞、Tb 1-Lu细胞、SW-1417细胞
"